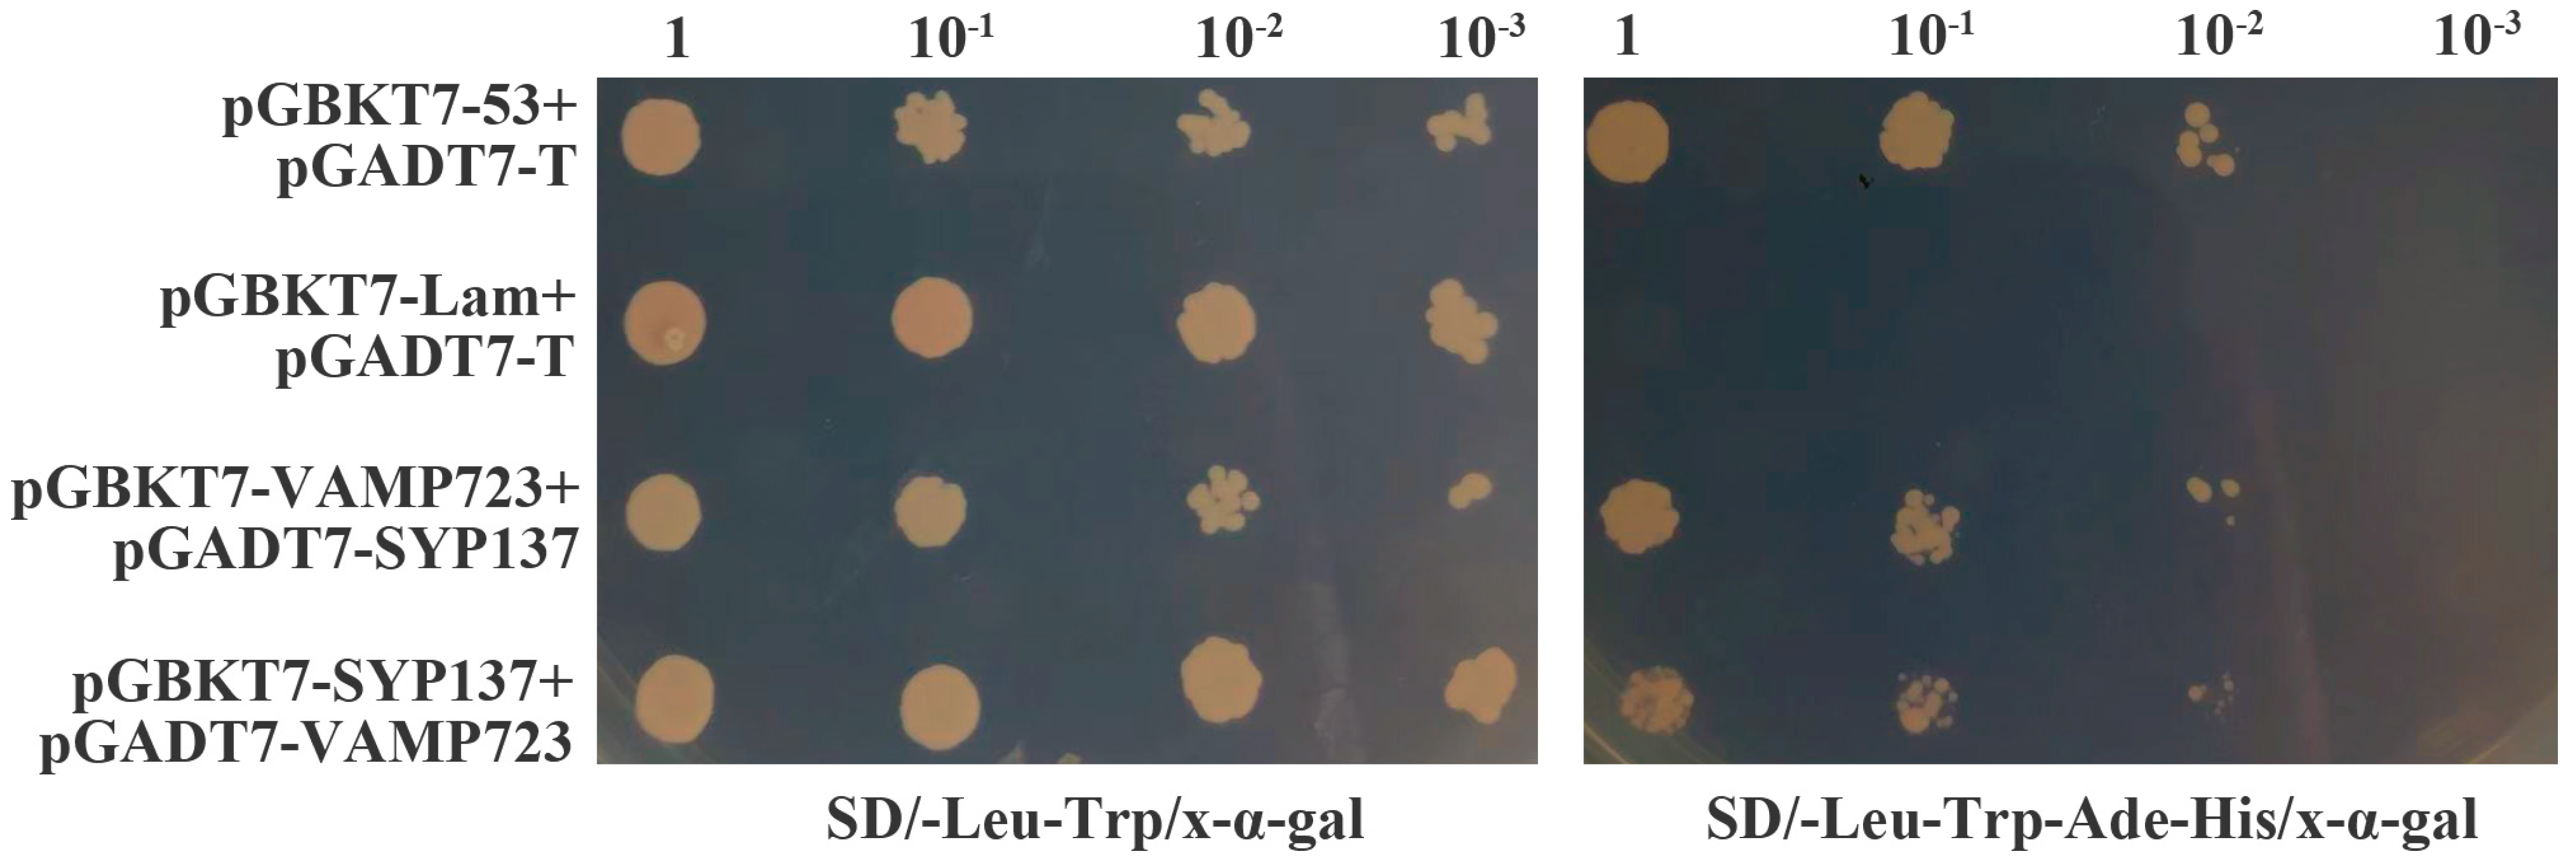
Ijms 24 04830 g006

TaSYP137 and TaVAMP723, the SNAREs Proteins from Wheat, Reduce Resistance to Blumeria graminis f. sp. tritici
Abstract
1. Introduction
2. Results
2.1. Isolation of Wheat TaSYP137 and TaVAMP723 and Characterization of the Encoding Proteins
2.2. Expression of TaSYP137 and TaVAMP723 in Wheat-Bgt and Their Subcellular Localization
2.3. Overexpression and Silencing of TaSYP137 and TaVAMP723 Substantiated Their Negative Roles in the Response of Wheat to Bgt
2.4. TaSYP137 Interacted with the TaVAMP723 Protein
3. Discussion
4. Materials and Methods
4.1. Plant Materials and Pathogen Stress Treatment
4.2. TaSYP137 and TaVAMP723 Cloning and Sequence Analysis
4.3. Real-Time Quantitative PCR Analysis
4.4. Vector Construction, Subcellular Localization, and Overexpression Assay
4.5. Gene Silencing Induced by Tobacco Transcribed BSMV RNA in Wheat
4.6. Yeast Two-Hybrid Assays
4.7. Statistical Analysis
5. Conclusions
Supplementary Materials
Author Contributions
Funding
Institutional Review Board Statement
Informed Consent Statement
Data Availability Statement
Acknowledgments
Conflicts of Interest
Abbreviations
| Bgt | Blumeria graminis f. sp. tritici |
| Bgh | Blumeria graminis f. sp. hordei |
| BSMV | Barley stripe mosaic virus |
| VIGS | Virus-induced gene silencing |
| Hpi | Hours post-inoculation |
| PM | Plasma membrane |
| Y2H | Yeast two-hybrid |
| dpi | Days post-infection |
References
- Jahn, R.; Scheller, R.H. SNAREs—Engines for membrane fusion. Nat. Rev. Mol. Cell Biol. 2006, 7, 631–643. [Google Scholar] [CrossRef]
- Lipka, V.; Kwon, C.; Panstruga, R. SNARE-Ware: The Role of SNARE-Domain Proteins in Plant Biology. Annu. Rev. Cell Dev. Biol. 2007, 23, 147–174. [Google Scholar] [CrossRef]
- Yun, H.S.; Kwon, C. Vesicle trafficking in plant immunity. Curr. Opin. Plant Biol. 2017, 40, 34–42. [Google Scholar] [CrossRef] [PubMed]
- Söllner, T.; Whiteheart, S.W.; Brunner, M.; Erdjument-Bromage, H.; Geromanos, S.; Tempst, P.; Rothman, J.E. SNAP receptors implicated in vesicle targeting and fusion. Nature 1993, 362, 318–324. [Google Scholar] [CrossRef] [PubMed]
- Bock, J.B.; Matern, H.T.; Peden, A.A.; Scheller, R.H. A genomic perspective on membrane compartment organization. Nature 2001, 409, 839–841. [Google Scholar] [CrossRef] [PubMed]
- Kwon, C.; Lee, J.-H.; Yun, H.S. SNAREs in Plant Biotic and Abiotic Stress Responses. Mol. Cells 2020, 43, 501–508. [Google Scholar]
- Yang, J.; Jin, H.; Liu, Y.; Guo, Y.; Zhang, Y. A dynamic template complex mediates Munc18-chaperoned SNARE assembly. Proc. Natl. Acad. Sci. USA 2022, 119, e2215124119. [Google Scholar] [CrossRef]
- Shaaban, A.; Dhara, M.; Frisch, W.; Harb, A.; Shaib, A.H.; Becherer, U.; Bruns, D.; Mohrmann, R. The SNAP-25 linker supports fusion intermediates by local lipid interactions. eLife 2019, 8, e41720. [Google Scholar] [CrossRef]
- Han, J.; Pluhackova, K.; Böckmann, R.A. The Multifaceted Role of SNARE Proteins in Membrane Fusion. Front. Physiol. 2017, 8, 5. [Google Scholar] [CrossRef]
- Zhu, M.; Xu, H.; Jiang, Y.; Yu, H.; Liu, Y. Epigallocatechin gallate inhibits SNARE-dependent membrane fusion by blocking trans-SNARE assembly. FEBS Open Bio. 2022, 12, 2111–2121. [Google Scholar] [CrossRef]
- Rubiato, H.M.; Liu, M.; O’Connell, R.J.; Nielsen, M.E. Plant SYP12 syntaxins mediate an evolutionarily conserved general immunity to filamentous pathogens. eLife 2022, 11, e73487. [Google Scholar] [CrossRef]
- Hückelhoven, R.; Panstruga, R. Cell biology of the plant–powdery mildew interaction. Curr. Opin. Plant Biol. 2011, 14, 738–746. [Google Scholar] [CrossRef] [PubMed]
- Assaad, F.F.; Qiu, J.-L.; Youngs, H.; Ehrhardt, D.; Zimmerli, L.; Kalde, M.; Wanner, G.; Peck, S.C.; Edwards, H.; Ramonell, K.; et al. The PEN1 Syntaxin Defines a Novel Cellular Compartment upon Fungal Attack and Is Required for the Timely Assembly of Papillae. Mol. Biol. Cell 2004, 15, 5118–5129. [Google Scholar] [CrossRef] [PubMed]
- Douchkov, D.; Nowara, D.; Zierold, U.; Schweizer, P. A High-Throughput Gene-Silencing System for the Functional Assessment of Defense-Related Genes in Barley Epidermal Cells. Mol. Plant-Microbe Interact. 2005, 18, 755–761. [Google Scholar] [CrossRef] [PubMed]
- Kwon, C.; Neu, C.; Pajonk, S.; Yun, H.S.; Lipka, U.; Humphry, M.; Bau, S.; Straus, M.; Kwaaitaal, M.; Rampelt, H.; et al. Co-option of a default secretory pathway for plant immune responses. Nature 2008, 451, 835–840. [Google Scholar] [CrossRef]
- Lipka, U.; Fuchs, R.; Lipka, V. Arabidopsis non-host resistance to powdery mildews. Curr. Opin. Plant Biol. 2008, 11, 404–411. [Google Scholar] [CrossRef] [PubMed]
- Wick, P.; Gansel, X.; Oulevey, C.; Page, V.; Studer, I.; Dürst, M.; Sticher, L. The Expression of the t-SNARE AtSNAP33 Is Induced by Pathogens and Mechanical Stimulation. Plant Physiol. 2003, 132, 343–351. [Google Scholar] [CrossRef]
- He, X.; Huo, Y.; Liu, X.; Zhou, Q.; Feng, S.; Shen, X.; Li, B.; Wu, S.; Chen, X. Activation of disease resistance against Botryosphaeria dothidea by downregulating the expression of MdSYP121 in apple. Hortic. Res. 2018, 5, 24. [Google Scholar] [CrossRef]
- Wang, X.; Wang, X.; Deng, L.; Chang, H.; Dubcovsky, J.; Feng, H.; Han, Q.; Huang, L.; Kang, Z. Wheat TaNPSN SNARE homologues are involved in vesicle-mediated resistance to stripe rust (Puccinia striiformis f. sp. tritici). J. Exp. Bot. 2014, 65, 4807–4820. [Google Scholar] [CrossRef]
- Eschen-Lippold, L.; Landgraf, R.; Smolka, U.; Schulze, S.; Heilmann, M.; Heilmann, I.; Hause, G.; Rosahl, S. Activation of defense against Phytophthora infestans in potato by down-regulation of syntaxin gene expression. New Phytol. 2012, 193, 985–996. [Google Scholar] [CrossRef]
- Sugano, S.; Hayashi, N.; Kawagoe, Y.; Mochizuki, S.; Inoue, H.; Mori, M.; Nishizawa, Y.; Jiang, C.-J.; Matsui, M.; Takatsuji, H. Rice OsVAMP714, a membrane-trafficking protein localized to the chloroplast and vacuolar membrane, is involved in resistance to rice blast disease. Plant Mol. Biol. 2016, 91, 81–95. [Google Scholar] [CrossRef]
- Chung, K.P.; Zeng, Y.; Li, Y.; Ji, C.; Xia, Y.; Jiang, L. Signal motifs-dependent ER export of Qc-SNARE BET12 interacts with MEMB12 and affects PR1 trafficking in Arabidopsis. J. Cell Sci. 2018, 131, jcs202838. [Google Scholar] [CrossRef] [PubMed]
- Ma, J.; Chen, J.; Wang, M.; Ren, Y.; Wang, S.; Lei, C.; Cheng, Z. Sodmergen, Disruption of OsSEC3A increases the content of salicylic acid and induces plant defense responses in rice. J. Exp. Bot. 2018, 69, 1051–1064. [Google Scholar] [CrossRef] [PubMed]
- Wang, G.; Long, D.; Yu, F.; Zhang, H.; Chen, C.; Wang, Y.; Ji, W. Genome-wide identification, evolution, and expression of the SNARE gene family in wheat resistance to powdery mildew. PeerJ 2021, 9, e10788. [Google Scholar] [CrossRef] [PubMed]
- Xue, Y.; Yang, Y.; Yang, Z.; Wang, X.; Guo, Y. VAMP711 Is Required for Abscisic Acid-Mediated Inhibition of Plasma Membrane H+-ATPase Activity. Plant Physiol. 2018, 178, 1332–1343. [Google Scholar] [CrossRef]
- Yun, H.S.; Kwaaitaal, M.; Kato, N.; Yi, C.; Park, S.; Sato, M.H.; Schulze-Lefert, P.; Kwon, C. Requirement of vesicle-associated membrane protein 721 and 722 for sustained growth during immune responses in Arabidopsis. Mol. Cells 2013, 35, 481–488. [Google Scholar] [CrossRef]
- Kim, S.; Park, K.; Kwon, C.; Yun, H.S. Synaptotagmin 4 and 5 additively contribute to Arabidopsis immunity to Pseudomonas syringae DC3000. Plant Signal. Behav. 2022, 17, 2025323. [Google Scholar] [CrossRef]
- El Kasmi, F.; Krause, C.; Hiller, U.; Stierhof, Y.D.; Mayer, U.; Conner, L.; Kong, L.; Reichardt, I.; Sanderfoot, A.A.; Jürgens, G. SNARE complexes of different composition jointly mediate membrane fusion in Arabidopsis cytokinesis. Mol. Biol. Cell 2013, 24, 1593–1601. [Google Scholar] [CrossRef]
- Kim, S.; Choi, Y.; Kwon, C.; Yun, H.S. Endoplasmic reticulum stress-induced accumulation of VAMP721/722 requires CALRETICULIN 1 and CALRETICULIN 2 in Arabidopsis. J. Integr. Plant Biol. 2019, 61, 974–980. [Google Scholar] [CrossRef]
- Yi, C.; Park, S.; Yun, H.S.; Kwon, C. Vesicle-associated membrane proteins 721 and 722 are required for unimpeded growth of Arabidopsis under ABA application. J. Plant Physiol. 2013, 170, 529–533. [Google Scholar] [CrossRef]
- Xia, L.; Marquès-Bueno, M.M.; Bruce, C.G.; Karnik, R. Unusual Roles of Secretory SNARE SYP132 in Plasma Membrane H+-ATPase Traffic and Vegetative Plant Growth. Plant Physiol. 2019, 180, 837–858. [Google Scholar] [CrossRef]
- Baena, G.; Xia, L.; Waghmare, S.; Karnik, R. SNARE SYP132 mediates divergent traffic of plasma membrane H+-ATPase AHA1 and antimicrobial PR1 during bacterial pathogenesis. Plant Physiol. 2022, 189, 1639–1661. [Google Scholar] [CrossRef] [PubMed]
- Kalde, M.; Nühse, T.S.; Findlay, K.; Peck, S.C. The syntaxin SYP132 contributes to plant resistance against bacteria and secretion of pathogenesis-related protein 1. Proc. Natl. Acad. Sci. USA 2007, 104, 11850–11855. [Google Scholar] [CrossRef] [PubMed]
- He, H.; Liu, R.; Ma, P.; Du, H.; Zhang, H.; Wu, Q.; Yang, L.; Gong, S.; Liu, T.; Huo, N.; et al. Characterization of Pm68, a new powdery mildew resistance gene on chro mosome 2BS of Greek durum wheat TRI 1796. Theor. Appl. Genet. 2021, 134, 53–62. [Google Scholar] [CrossRef] [PubMed]
- Hewitt, T.; Müller, M.C.; Molnár, I.; Mascher, M.; Holušová, K.; Šimková, H.; Kunz, L.; Zhang, J.; Li, J.; Bhatt, D.; et al. A highly differentiated region of wheat chromosome 7AL encodes a Pm1a immune receptor that recognizes its corresponding AvrPm1a effector from Blumeria graminis. New Phytol. 2021, 229, 2812–2826. [Google Scholar] [CrossRef]
- Sánchez-Martín, J.; Widrig, V.; Herren, G.; Wicker, T.; Zbinden, H.; Gronnier, J.; Spörri, L.; Praz, C.R.; Heuberger, M.; Kolodziej, M.C.; et al. Wheat Pm4 resistance to powdery mildew is controlled by alternative splice variants encoding chimeric proteins. Nat. Plants 2021, 7, 327–341. [Google Scholar] [CrossRef] [PubMed]
- Sánchez-Martín, J.; Steuernagel, B.; Ghosh, S.; Herren, G.; Hurni, S.; Adamski, N.; Vrána, J.; Kubaláková, M.; Krattinger, S.G.; Wicker, T.; et al. Rapid gene isolation in barley and wheat by mutant chromosome sequencing. Genome Biol. 2016, 17, 221. [Google Scholar] [CrossRef] [PubMed]
- Lu, P.; Guo, L.; Wang, Z.; Li, B.; Li, J.; Li, Y.; Qiu, D.; Shi, W.; Yang, L.; Wang, N.; et al. A rare gain of function mutation in a wheat tandem kinase confers resistance to powdery mildew. Nat. Commun. 2020, 11, 680. [Google Scholar] [CrossRef]
- Li, M.; Dong, L.; Li, B.; Wang, Z.; Xie, J.; Qiu, D.; Li, Y.; Shi, W.; Yang, L.; Wu, Q.; et al. A CNL protein in wild emmer wheat confers powdery mildew resistance. New Phytol. 2020, 228, 1027–1037. [Google Scholar] [CrossRef]
- Cao, A.; Xing, L.; Wang, X.; Yang, X.; Wang, W.; Sun, Y.; Qian, C.; Ni, J.; Chen, Y.; Liu, D.; et al. Serine/threonine kinase gene Stpk-V, a key member of powdery mildew resistance gene Pm21, confers powdery mildew resistance in wheat. Proc. Natl. Acad. Sci. USA 2011, 108, 7727–7732. [Google Scholar] [CrossRef]
- Hurni, S.; Brunner, S.; Buchmann, G.; Herren, G.; Jordan, T.; Krukowski, P.; Wicker, T.; Yahiaoui, N.; Mago, R.; Keller, B. Rye Pm8 and wheat Pm3 are orthologous genes and show evolutionary conservation of resistance function against powdery mildew. Plant J. 2013, 76, 957–969. [Google Scholar] [CrossRef] [PubMed]
- Chen, T.; Xiao, J.; Xu, J.; Wan, W.; Qin, B.; Cao, A.; Chen, W.; Xing, L.; Du, C.; Gao, X.; et al. Two members of TaRLK family confer powdery mildew resistance in common wheat. BMC Plant Biol. 2016, 16, 27. [Google Scholar] [CrossRef] [PubMed]
- Zou, B.; Ding, Y.; Liu, H.; Hua, J. Silencing of copine genes confers common wheat enhanced resistance to powdery mildew. Mol. Plant Pathol. 2018, 19, 1343–1352. [Google Scholar] [CrossRef]
- Jordan, T.; Seeholzer, S.; Schwizer, S.; Töller, A.; Somssich, I.E.; Keller, B. The wheat Mla homologue TmMla1 exhibits an evolutionarily conserved function against powdery mildew in both wheat and barley. Plant J. 2011, 65, 610–621. [Google Scholar] [CrossRef] [PubMed]
- Jing, Y.; Liu, J.; Liu, P.; Ming, D.; Sun, J. Overexpression of TaJAZ1 increases powdery mildew resistance through promoting reactive oxygen species accumulation in bread wheat. Sci. Rep. 2019, 9, 5691. [Google Scholar] [CrossRef] [PubMed]
- Zhou, W.; Qian, C.; Li, R.; Zhou, S.; Zhang, R.; Xiao, J.; Wang, X.; Zhang, S.; Xing, L.; Cao, A. TaNAC6s are involved in the basal and broad-spectrum resistance to powdery mildew in wheat. Plant Sci. 2018, 277, 218–228. [Google Scholar] [CrossRef]
- Hu, P.; Liu, J.; Xu, J.; Zhou, C.; Cao, S.; Zhou, W.; Huang, Z.; Yuan, S.; Wang, X.; Xiao, J.; et al. A malectin-like/leucine-rich repeat receptor protein kinase gene, RLK-V, regulates powdery mildew resistance in wheat. Mol. Plant Pathol. 2018, 19, 2561–2574. [Google Scholar] [CrossRef]
- Chen, G.; Wei, B.; Li, G.; Gong, C.; Fan, R.; Zhang, X. TaEDS1 genes positively regulate resistance to powdery mildew in wheat. Plant Mol. Biol. 2018, 96, 607–625. [Google Scholar] [CrossRef]
- Zhang, X.; Wang, G.; Qu, X.; Wang, M.; Guo, H.; Zhang, L.; Li, T.; Wang, Y.; Zhang, H.; Ji, W. A truncated CC-NB-ARC gene TaRPP13L1-3D positively regulates powdery mildew resistance in wheat via the RanGAP-WPP complex-mediated nucleocytoplasmic shuttle. Planta 2022, 255, 60. [Google Scholar] [CrossRef]
- Liu, J.; Zhang, T.; Jia, J.; Sun, J. The Wheat Mediator Subunit TaMED25 Interacts with the Transcription Factor TaEIL1 to Negatively Regulate Disease Resistance against Powdery Mildew. Plant Physiol. 2016, 170, 1799–1816. [Google Scholar] [CrossRef]
- Yue, J.; Sun, H.; Zhang, W.; Pei, D.; He, Y.; Wang, H. Wheat homologs of yeast ATG6 function in autophagy and are implicated in powdery mildew immunity. BMC Plant Biol. 2015, 15, 95. [Google Scholar] [CrossRef]
- Zheng, H.; Dong, L.; Han, X.; Jin, H.; Yin, C.; Han, Y.; Li, B.; Qin, H.; Zhang, J.; Shen, Q.; et al. The TuMYB46L-TuACO3 module regulates ethylene biosynthesis in einkorn wheat defense to powdery mildew. New Phytol. 2020, 225, 2526–2541. [Google Scholar] [CrossRef]
- Sanderfoot, A. Increases in the Number of SNARE Genes Parallels the Rise of Multicellularity among the Green Plants. Plant Physiol. 2007, 144, 6–17. [Google Scholar] [CrossRef]
- Kim, S.; Kim, H.; Park, K.; Cho, D.J.; Kim, M.K.; Kwon, C.; Yun, H.S. Synaptotagmin 5 Controls SYP132-VAMP721/722 Interaction for Arabidopsis Immunity to Pseudomonas syringae pv tomato DC3000. Mol. Cells 2021, 44, 670–679. [Google Scholar] [CrossRef]
- Ichikawa, M.; Hirano, T.; Enami, K.; Fuselier, T.; Kato, N.; Kwon, C.; Voigt, B.; Schulze-Lefert, P.; Baluška, F.; Sato, M.H. Syntaxin of Plant Proteins SYP123 and SYP132 Mediate Root Hair Tip Growth in Arabidopsis thaliana. Plant Cell Physiol. 2014, 55, 790–800. [Google Scholar] [CrossRef]
- Yu, X.; Lund, S.P.; Scott, R.A.; Greenwald, J.W.; Records, A.H.; Nettleton, D.; Lindow, S.E.; Gross, D.C.; Beattie, G.A. Transcriptional responses of Pseudomonas syringae to growth in epiphytic versus apoplastic leaf sites. Proc. Natl. Acad. Sci. USA 2013, 110, E425–E434. [Google Scholar] [CrossRef]
- Xing, J.; Li, X.; Wang, X.; Lv, X.; Wang, L.; Zhang, L.; Zhu, Y.; Shen, Q.; Baluška, F.; Šamaj, J.; et al. Secretion of Phospholipase Dδ Functions as a Regulatory Mechanism in Plant Innate Immunity. Plant Cell 2019, 31, 3015–3032. [Google Scholar] [CrossRef] [PubMed]
- Kim, H.; O’Connell, R.; Maekawa-Yoshikawa, M.; Uemura, T.; Neumann, U.; Schulze-Lefert, P. The powdery mildew resistance protein RPW8.2 is carried on VAMP721/722 vesicles to the extrahaustorial membrane of haustorial complexes. Plant J. 2014, 79, 835–847. [Google Scholar] [CrossRef] [PubMed]
- Cao, W.-L.; Yu, Y.; Li, M.-Y.; Luo, J.; Wang, R.-S.; Tang, H.-J.; Huang, J.; Wang, J.-F.; Zhang, H.-S.; Bao, Y.-M. OsSYP121 Accumulates at Fungal Penetration Sites and Mediates Host Resistance to Rice Blast. Plant Physiol. 2019, 179, 1330–1342. [Google Scholar] [CrossRef] [PubMed]
- Feechan, A.; Jermakow, A.M.; Ivancevic, A.; Godfrey, D.; Pak, H.; Panstruga, R.; Dry, I.B. Host Cell Entry of Powdery Mildew Is Correlated with Endosomal Transport of Antagonistically Acting VvPEN1 and VvMLO to the Papilla. Mol. Plant-Microbe Interact. 2013, 26, 1138–1150. [Google Scholar] [CrossRef]
- Bracuto, V.; Appiano, M.; Zheng, Z.; Wolters, A.-M.; Yan, Z.; Ricciardi, L.; Visser, R.G.F.; Pavan, S.; Bai, Y. Functional Characterization of a Syntaxin Involved in Tomato (Solanum lycopersicum) Resistance against Powdery Mildew. Front. Plant Sci. 2017, 8, 1573. [Google Scholar] [CrossRef] [PubMed]
- Xue, F.; Ji, W.; Wang, C.; Zhang, H.; Yang, B. High-density mapping and marker development for the powdery mildew resistance gene PmAS846 derived from wild emmer wheat (Triticum turgidum var. dicoccoides). Theor. Appl. Genet. 2012, 124, 1549–1560. [Google Scholar] [CrossRef] [PubMed]
- Guo, H.; Zhang, H.; Wang, G.; Wang, C.; Wang, Y.; Liu, X.; Ji, W. Identification and expression analysis of heat-shock proteins in wheat infected with powdery mildew and stripe rust. Plant Genome 2021, 14, e20092. [Google Scholar] [CrossRef] [PubMed]
- Barry, D.J.; Chan, C.; Williams, G.A. Morphological quantification of filamentous fungal development using membrane immobilization and automatic image analysis. J. Ind. Microbiol. Biotechnol. 2009, 36, 787–800. [Google Scholar] [CrossRef] [PubMed]

Disclaimer/Publisher’s Note: The statements, opinions and data contained in all publications are solely those of the individual author(s) and contributor(s) and not of MDPI and/or the editor(s). MDPI and/or the editor(s) disclaim responsibility for any injury to people or property resulting from any ideas, methods, instructions or products referred to in the content. |
© 2023 by the authors. Licensee MDPI, Basel, Switzerland. This article is an open access article distributed under the terms and conditions of the Creative Commons Attribution (CC BY) license (https://creativecommons.org/licenses/by/4.0/).
Share and Cite
Wang, G.; Zhang, X.; Guo, H.; Zhao, C.; Zhang, H.; Chen, C.; Ji, W. TaSYP137 and TaVAMP723, the SNAREs Proteins from Wheat, Reduce Resistance to Blumeria graminis f. sp. tritici. Int. J. Mol. Sci. 2023, 24, 4830. https://doi.org/10.3390/ijms24054830
Wang G, Zhang X, Guo H, Zhao C, Zhang H, Chen C, Ji W. TaSYP137 and TaVAMP723, the SNAREs Proteins from Wheat, Reduce Resistance to Blumeria graminis f. sp. tritici. International Journal of Molecular Sciences. 2023; 24(5):4830. https://doi.org/10.3390/ijms24054830
Chicago/Turabian StyleWang, Guanghao, Xiangyu Zhang, Huan Guo, Chenxu Zhao, Hong Zhang, Chunhuan Chen, and Wanquan Ji. 2023. "TaSYP137 and TaVAMP723, the SNAREs Proteins from Wheat, Reduce Resistance to Blumeria graminis f. sp. tritici" International Journal of Molecular Sciences 24, no. 5: 4830. https://doi.org/10.3390/ijms24054830
APA StyleWang, G., Zhang, X., Guo, H., Zhao, C., Zhang, H., Chen, C., & Ji, W. (2023). TaSYP137 and TaVAMP723, the SNAREs Proteins from Wheat, Reduce Resistance to Blumeria graminis f. sp. tritici. International Journal of Molecular Sciences, 24(5), 4830. https://doi.org/10.3390/ijms24054830

